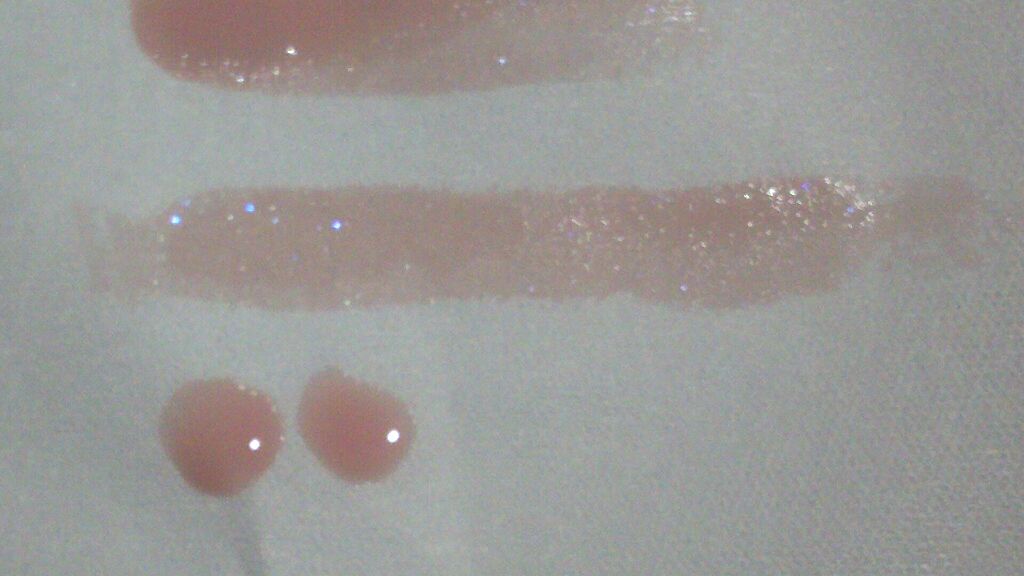
ミニネイル/パラドゥ/マニキュアを使ったクチコミ(3枚目)

ミニネイル25周年夏新色「幻想夢見花」❤︎︎︎︎❤︎パラドゥミニネイル❤︎︎︎︎❤︎6.20金曜日新発売パラドゥ25周年の夏を飾るのはそんな楽園から生まれたとっておきのネイルカラー⸜❤️⸝RD14恋心甘々メロメロウ大人の顔して無邪気その二面性...
もっと見るおすすめアイテムパラドゥ×マニキュア
| 商品画像 | 商品情報 | 参考価格 | 評価 | ランキングIN | 特徴 | 商品リンク |
|---|---|---|---|---|---|---|
パラドゥ ミニネイル | 385円 |
| ネイルランキング第10位 | トップコートもしてないのにツヤッツヤで、塗りムラが目立たない! | 詳細を見る | |
パラドゥ ネイルファンデーション | 550円 |
| ネイルランキング第24位 | びっくりするくらいの速乾性!ひと塗りで、丁寧に磨いたようなぴかぴか感 | 詳細を見る | |
パラドゥ パラドゥ グリッタリーネイル | 495円 |
| ネイルランキング第82位 | 詳細を見る |
マニキュアランキング
| 商品画像 | 商品情報 | 参考価格 | 評価 | ランキングIN | 特徴 | 商品リンク |
|---|---|---|---|---|---|---|
キャンメイク カラフルネイルズ | 396円 |
| ネイルランキング第1位 | 塗りやすさも👌🏻ワンカラーでも プチプラとは思えない仕上がりです🤤💓 | 詳細を見る | |
キャンメイク ファンデーションカラーズ | 396円 |
| ネイルランキング第4位 | シアー感たっぷりのちゅるんネイルが簡単に出来るのでオススメです🤍 | 詳細を見る | |
CHANEL ヴェルニ | 3,300円 |
| ネイルランキング第5位 | 見たまま発色、乾きの速さ!ハケは細めで細かいところまでサラサラとキレイに塗ることができる | 詳細を見る | |
パラドゥ ミニネイル | 385円 |
| ネイルランキング第10位 | トップコートもしてないのにツヤッツヤで、塗りムラが目立たない! | 詳細を見る | |
Causette.Joli Coeur de Fleur Nail Color | 1,980円 |
| ネイルランキング第11位 | ムラにならずに均一に色が乗って、なかなかない色味! | 詳細を見る | |
デュカート ネイルマイン | 495円 |
| ネイルランキング第16位 | 大きく広がる筆がササッと3ストロークで塗れる上に、筆先がラウンドタイプなので根元もきれいに仕上げられるのが嬉しい | 詳細を見る | |
SUQQU ネイル カラー ポリッシュ | 2,750円 |
| ネイルランキング第14位 | 1度塗りでムラなくしっかり発色!ネイルが乾きながらフラットな爪にしてくれる♪ | 詳細を見る | |
ネイルホリック ネイルホリック | 330円 |
| ネイルランキング第18位 | とにかく乾きが早い!ムラなく塗れる!初心者さんやネイルが苦手な方でも | 詳細を見る | |
ちふれ ネイル エナメル | 440円 |
| ネイルランキング第17位 | ちふれのポリッシュは 筆も塗りやすく速乾なので ネイルはじめてさんにも👌🏻 ̖́- | 詳細を見る | |
パラドゥ ネイルファンデーション | 550円 |
| ネイルランキング第24位 | びっくりするくらいの速乾性!ひと塗りで、丁寧に磨いたようなぴかぴか感 | 詳細を見る |
くるるんさんの人気クチコミ
眉毛が濃い人に朗報。私は眉毛が濃すぎるのが悩み。そのためペンシルアイブロウが大の苦手でパウダーばかり使いアイブロウマスカラで仕上げてきました。ただ濃いのに所々生えてない隙間がある。何かで塗りつぶすと何故か不自然に濃くなったりで変になる‥。修正...
もっと見る
101
47
- 2019.03.21
一生身に纏うであろう香水。リラックスしたいときに欠かせない一品。モスキーノのアイラブラブと香りが似ている。...
もっと見る
69
11
- 2019.06.07
先日エレガンスでタッチアップしてもらいました。エレガンスラプードルオートニュアンスリクスィーズⅠエレガント二番目の画像は、頬と首までです。首が焼けやすいのですが、Ⅰだと首との境目が変にならないし顔だけ白くならない。色馴染みがとてもいいです。昔...
もっと見る
60
21
- 2019.04.23
「SPF50+PA++++」疑り深い私‥‥100%そうは思えないところがあります。ということで、焼けにくい日焼け止め代表格、アネッサとアリーの成分をみて、本当に焼けにくいって何なのか。比較したいなと思います。ちなみに両方ともSPF50+SPF...
もっと見る
56
7
- 2019.04.21
今日は、マキアージュのドラマティックルージュEXを使用した鮮やかなピンクで攻めるぱきっとしたメイクです。※3枚目、口唇にルージュを塗せた写真です。4枚目、目元の写真。目つきがよくないので瞳はアニメ風に加工しております。ドラマティックルージュE...
もっと見る
55
0
- 2019.04.05
コフレドールスキンシンクロルージュBE-239基本的にベージュはつけない主義です。ほぼ口紅はピンクをつけてます。かれこれ何度もトライしたけど、顔がくすんだりヌーディすぎて天ぷら食べたあとみたいになったり野暮ったくて敗北。マキアージュのジェルル...
もっと見る
52
9
- 2019.03.26
商品詳細情報パラドゥ ミニネイル
- ブランド名
- パラドゥ(Parado)
- ランキングIN
- 全体ランキング年代別ランキング
- 容量・参考価格
- 4.0ml: 385円
- 4.0ml(12星座エレメント): 440円
- 取扱店舗
- 近くのパラドゥ取扱店舗はこちら
- バリエーション
- 商品説明
- トレンドカラーを気軽に試せる、ワンシーズン使い切りサイズのミニネイル。ファッションや、気分に合わせ、思いのままに爪の色を着替えたい大人の女性にふさわしいネイルカラーです。はがれの原因のひとつである「水によるふやけ」に強い、耐水性の高い樹脂を採用し、きれいな色ツヤが続きます。平筆で塗りやすく、お直しの時にも助かる速乾タイプ。持ち歩きにも便利なミニサイズ。
- メーカー名
- パラドゥ
- 発売日
- 2018/9/26(最新発売日: 2025/11/28)
- 成分
- <YE02 ムーンライトソルト> 酢酸ブチル、酢酸エチル、ニトロセルロース、クエン酸アセチルトリブチル、(無水フタル酸/無水トリメリト酸/グリコールズ)コポリマー、イソプロパノール、安息香酸スクロース、ステアラルコニウムヘクトライト、パンテノール、(アジピン酸/ネオペンチルグリコール/無水トリメリト酸)コポリマー、PEG-3ヤシ脂肪酸アミドMEA硫酸Na、t-ブチルメトキシジベンゾイルメタン、水、カンフル、クエン酸、シメチコン、ジ(C12-15)パレス-2リン酸、ジ安息香酸DPG、ステアラルコニウムベントナイト、タルク、トリエトキシカプリリルシラン、パーフルオロヘキシルエチルトリエトキシシラン、メチコン、メトキシケイヒ酸エチルヘキシル、BHT、オキシベンゾン-3、酸化チタン、水酸化Al、シリカ、マイカ、酸化鉄、コンジョウ、赤202、黄4 <BK02 ナイトペッパー> 酢酸ブチル、ニトロセルロース、酢酸エチル、クエン酸アセチルトリブチル、イソプロパノール、(無水フタル酸/無水トリメリト酸/グリコールズ)コポリマー、シリカ、安息香酸スクロース、ブタノール、パンテノール、(アジピン酸/ネオペンチルグリコール/無水トリメリト酸)コポリマー、PEG-3ヤシ脂肪酸アミドMEA硫酸Na、水、シメチコン、ジ(C12-15)パレス-2リン酸、ジ安息香酸DPG、ステアラルコニウムベントナイト、トリエトキシカプリリルシラン、メチコン、酸化チタン、水酸化Al、コンジョウ、酸化鉄、カーボンブラック、(PET/ポリメタクリル酸メチル)ラミネート、赤202、黄4、紫201、ポリウレタン-11、PET <GN06 テネシークーラー> 酢酸ブチル、酢酸エチル、ニトロセルロース、クエン酸アセチルトリブチル、(無水フタル酸/無水トリメリト酸/グリコールズ)コポリマー、イソプロパノール、安息香酸スクロース、ステアラルコニウムヘクトライト、パンテノール、(アジピン酸/ネオペンチルグリコール/無水トリメリト酸)コポリマー、PEG-3ヤシ脂肪酸アミドMEA硫酸Na、t-ブチルメトキシジベンゾイルメタン、水、カンフル、クエン酸、シメチコン、ジ(C12-15)パレス-2リン酸、ジ安息香酸DPG、ステアラルコニウムベントナイト、トリエトキシカプリリルシラン、メチコン、メトキシケイヒ酸エチルヘキシル、BHT、オキシベンゾン-3、酸化チタン、水酸化Al、コンジョウ、酸化鉄、赤202、黄4 <PK17 フラミンゴレディ> 酢酸ブチル、酢酸エチル、ニトロセルロース、クエン酸アセチルトリブチル、(無水フタル酸/無水トリメリト酸/グリコールズ)コポリマー、イソプロパノール、安息香酸スクロース、ステアラルコニウムヘクトライト、パンテノール、(アジピン酸/ネオペンチルグリコール/無水トリメリト酸)コポリマー、PEG-3ヤシ脂肪酸アミドMEA硫酸Na、t-ブチルメトキシジベンゾイルメタン、水、カンフル、クエン酸、シメチコン、ジ(C12-15)パレス-2リン酸、ジ安息香酸DPG、ステアラルコニウムベントナイト、タルク、トリエトキシカプリリルシラン、メチコン、メトキシケイヒ酸エチルヘキシル、BHT、オキシベンゾン-3、酸化チタン、水酸化Al、酸化鉄、コンジョウ、マンガンバイオレット、赤202、赤226、黄4 <PK18 ピンクスクァーレル> 酢酸ブチル、酢酸エチル、ニトロセルロース、クエン酸アセチルトリブチル、(無水フタル酸/無水トリメリト酸/グリコールズ)コポリマー、イソプロパノール、安息香酸スクロース、ステアラルコニウムヘクトライト、パンテノール、(アジピン酸/ネオペンチルグリコール/無水トリメリト酸)コポリマー、PEG-3ヤシ脂肪酸アミドMEA硫酸Na、t-ブチルメトキシジベンゾイルメタン、水、カンフル、クエン酸、シメチコン、ジ(C12-15)パレス-2リン酸、ジ安息香酸DPG、ステアラルコニウムベントナイト、タルク、トリエトキシカプリリルシラン、パーフルオロヘキシルエチルトリエトキシシラン、メチコン、メトキシケイヒ酸エチルヘキシル、BHT、オキシベンゾン-3、酸化スズ、酸化チタン、水酸化Al、酸化鉄、コンジョウ、マンガンバイオレット、ホウケイ酸(Ca/Al)、赤202、黄4 <BR09 カカオフィズ> 酢酸ブチル、酢酸エチル、ニトロセルロース、クエン酸アセチルトリブチル、(無水フタル酸/無水トリメリト酸/グリコールズ)コポリマー、イソプロパノール、安息香酸スクロース、ステアラルコニウムヘクトライト、パンテノール、(アジピン酸/ネオペンチルグリコール/無水トリメリト酸)コポリマー、PEG-3ヤシ脂肪酸アミドMEA硫酸Na、t-ブチルメトキシジベンゾイルメタン、水、カンフル、クエン酸、シメチコン、ジ(C12-15)パレス-2リン酸、ジ安息香酸DPG、ステアラルコニウムベントナイト、タルク、トリエトキシカプリリルシラン、メチコン、メトキシケイヒ酸エチルヘキシル、BHT、オキシベンゾン-3、酸化スズ、酸化チタン、水酸化Al、酸化鉄、コンジョウ、ホウケイ酸(Ca/Al)、赤202、赤226、黄4 <OR05 ルーセント フラワー> 酢酸ブチル、酢酸エチル、ニトロセルロース、クエン酸アセチルトリブチル、イソプロパノール、安息香酸スクロース、アクリレーツコポリマー、シリカ、カンフル、PET、水、ジメチコン、オキシベンゾン-3、酸化スズ、酸化鉄、ホウケイ酸(Ca/Na) <GD05 ダズリング スター> 酢酸ブチル、酢酸エチル、ニトロセルロース、クエン酸アセチルトリブチル、イソプロパノール、安息香酸スクロース、シリカ、アルキッド-2、(無水フタル酸/無水トリメリト酸/グリコールズ)コポリマー、カンフル、水、アクリレーツコポリマー、ジメチコン、ステアラルコニウムヘクトライト、ブタノール、酸化スズ、酸化チタン、酸化鉄、ホウケイ酸(Ca/Na) <PL09 ラブド ワン> 酢酸ブチル、酢酸エチル、ニトロセルロース、クエン酸アセチルトリブチル、イソプロパノール、安息香酸スクロース、シリカ、アルキッド-2、(無水フタル酸/無水トリメリト酸/グリコールズ)コポリマー、カンフル、合成フルオロフロゴパイト、水、アクリレーツコポリマー、ジメチコン、ステアラルコニウムヘクトライト、ブタノール、酸化スズ、酸化チタン、金、マンガンバイオレット、ホウケイ酸(Ca/Al)、ホウケイ酸(Ca/Na) <BL14 ミッドナイト スカイ> 酢酸ブチル、酢酸エチル、ニトロセルロース、クエン酸アセチルトリブチル、イソプロパノール、安息香酸スクロース、カンフル、アルキッド-2、(無水フタル酸/無水トリメリト酸/グリコールズ)コポリマー、シリカ、t-ブチルメトキシジベンゾイルメタン、水、アクリレーツコポリマー、ジメチコン、ステアラルコニウムヘクトライト、ブタノール、メトキシケイヒ酸エチルヘキシル、BHT、オキシベンゾン-3、酸化チタン、コンジョウ、酸化鉄 <GN05 サイレント アース> 酢酸ブチル、酢酸エチル、ニトロセルロース、クエン酸アセチルトリブチル、イソプロパノール、安息香酸スクロース、カンフル、アルキッド-2、(無水フタル酸/無水トリメリト酸/グリコールズ)コポリマー、シリカ、t-ブチルメトキシジベンゾイルメタン、水、アクリレーツコポリマー、ジメチコン、ステアラルコニウムヘクトライト、パーフルオロヘキシルエチルトリエトキシシラン、ブタノール、メトキシケイヒ酸エチルヘキシル、BHT、オキシベンゾン-3、酸化鉄、コンジョウ <RD12 ギャラクシー マジック> 酢酸ブチル、酢酸エチル、ニトロセルロース、クエン酸アセチルトリブチル、イソプロパノール、安息香酸スクロース、カンフル、アルキッド-2、(無水フタル酸/無水トリメリト酸/グリコールズ)コポリマー、シリカ、t-ブチルメトキシジベンゾイルメタン、水、硫酸Ba、アクリレーツコポリマー、ジメチコン、ステアラルコニウムヘクトライト、ブタノール、メトキシケイヒ酸エチルヘキシル、BHT、オキシベンゾン-3、マロン酸ビスエチルヘキシルヒドロキシジメトキシベンジル、酸化チタン、酸化鉄、コンジョウ、赤405
![LIPS[リップス] - コスメのクチコミ検索アプリ](https://cdn.lipscosme.com/assets/lips_logo_full_2022-bc7b4bc9dd66035bc5696b0d16bc3d38a7be357186656c039e68cc4cf21ae675.png)

コメント